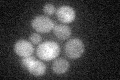
YJR047C
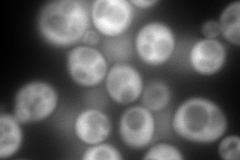
YJR047C
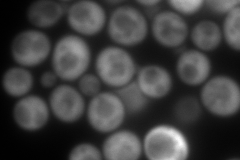
YJR047C
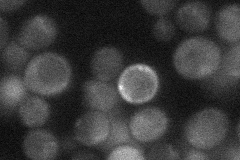
YJR047C
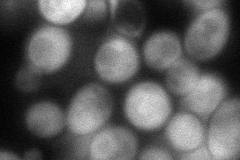
YJR047C
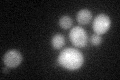
YJR047C
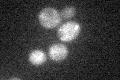
YJR047C

View description
Translation elongation factor eIF-5A, previously thought to function in translation initiation; similar to and functionally redundant with Hyp2p; undergoes an essential hypusination modification; expressed under anaerobic conditions
Localization:
Intensity:
Fold change:
Significance:
-
C’ GFP library in SD
cytosol26.44 -
N' NOP1pr-GFP in SD
cytosol455.668 -
N' TEF2pr-mCherry in SD
cytosol701.403 -
N' NATIVEpr-GFP in SD
below threshold25.0883 -
N' TEF2pr-VC and Cyto-VN in SD
cytosol88.5312 -
C’ GFP library in SD+DTT
cytosol20.240.76No -
C’ GFP library in SD+H2O2
cytosol21.380.8No -
C’ GFP library in Starvation Media

cytosol18.260.69No -
C’ GFP library on the background of Pup2-DaMP

cytosol -
C’ GFP library on the background of CCT mutant

cytosol25.18160.95236No
